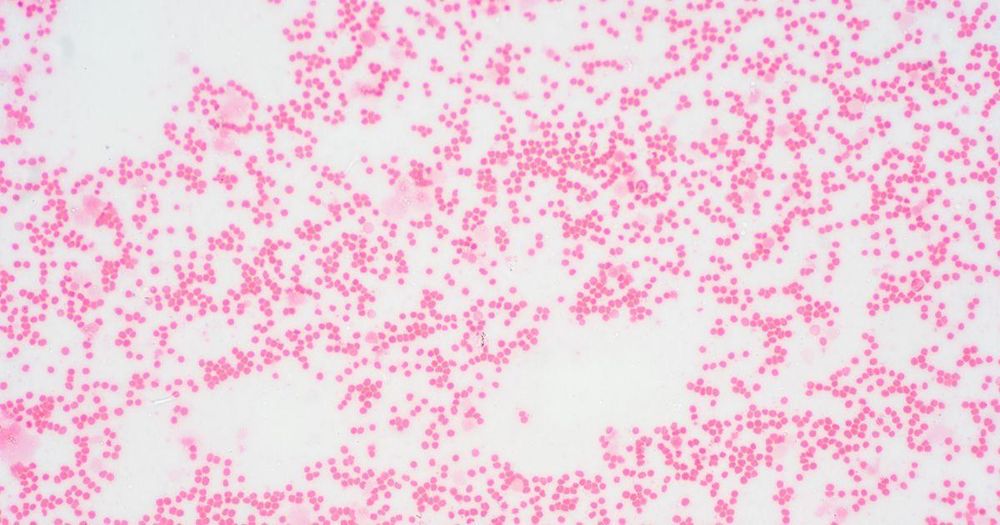

10x Genomics
@10xgenomics.bsky.social
1.3K followers
35 following
180 posts
Enabling researchers to answer biology’s hardest and most elusive questions with innovative #singlecell, #spatialbiology & #insitu technology.
Posts
Media
Videos
Starter Packs
Pinned
10x Genomics
@10xgenomics.bsky.social
· Jan 7